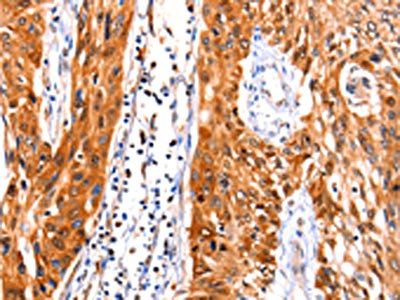

FBLN1 Antibody
-
中文名稱:FBLN1兔多克隆抗體
-
貨號:CSB-PA016832
-
規(guī)格:¥1100
-
圖片:
-
The image on the left is immunohistochemistry of paraffin-embedded Human esophagus cancer tissue using CSB-PA016832(FBLN1 Antibody) at dilution 1/47, on the right is treated with synthetic peptide. (Original magnification: ×200)
-
The image on the left is immunohistochemistry of paraffin-embedded Human liver cancer tissue using CSB-PA016832(FBLN1 Antibody) at dilution 1/47, on the right is treated with synthetic peptide. (Original magnification: ×200)
-
-
其他:
產(chǎn)品詳情
-
Uniprot No.:
-
基因名:
-
別名:Basement membrane protein 90 antibody; BM 90 antibody; FBLN antibody; Fbln1 antibody; FBLN1_HUMAN antibody; FIBL 1 antibody; FIBL-1 antibody; FIBL1 antibody; Fibulin 1 antibody; Fibulin-1 antibody
-
宿主:Rabbit
-
反應(yīng)種屬:Human
-
免疫原:Synthetic peptide of Human FBLN1
-
免疫原種屬:Homo sapiens (Human)
-
標(biāo)記方式:Non-conjugated
-
抗體亞型:IgG
-
純化方式:Antigen affinity purification
-
濃度:It differs from different batches. Please contact us to confirm it.
-
保存緩沖液:-20°C, pH7.4 PBS, 0.05% NaN3, 40% Glycerol
-
產(chǎn)品提供形式:Liquid
-
應(yīng)用范圍:ELISA,IHC
-
推薦稀釋比:
Application Recommended Dilution ELISA 1:1000-1:10000 IHC 1:100-1:300 -
Protocols:
-
儲存條件:Upon receipt, store at -20°C or -80°C. Avoid repeated freeze.
-
貨期:Basically, we can dispatch the products out in 1-3 working days after receiving your orders. Delivery time maybe differs from different purchasing way or location, please kindly consult your local distributors for specific delivery time.
-
用途:For Research Use Only. Not for use in diagnostic or therapeutic procedures.
相關(guān)產(chǎn)品
靶點詳情
-
功能:Incorporated into fibronectin-containing matrix fibers. May play a role in cell adhesion and migration along protein fibers within the extracellular matrix (ECM). Could be important for certain developmental processes and contribute to the supramolecular organization of ECM architecture, in particular to those of basement membranes. Has been implicated in a role in cellular transformation and tumor invasion, it appears to be a tumor suppressor. May play a role in haemostasis and thrombosis owing to its ability to bind fibrinogen and incorporate into clots. Could play a significant role in modulating the neurotrophic activities of APP, particularly soluble APP.
-
基因功能參考文獻:
- FBLN1 and STK31 can be possible screening and differentiating biomarkers of colorectal cancer PMID: 29715435
- Fibulin-1 is expressed in breast cancer cell lines, interacts wtih SHBG, and is increased by estradiol PMID: 29940241
- This study demonstrated that FBLN1 can effectively promote osteogenic differentiation of human nasal inferior turbinate-derived mesenchymal stem cells into osteoblasts. PMID: 28445604
- This study demonstrated that fibulin-1 (FBLN1) was detected in the serums of Alzheimer disease patients PMID: 27911324
- Interestingly and in contrast with our expectation, we found that the expression level of FBLN-4 and BCRP were downregulated in tumor compared to adjacent normal tissues. FBLN-4 was associated with grade histology and therefore can be considered as a potential prognostic biomarker. PMID: 28282800
- Serum and vitreous fibulin-1 concentrations are elevated under diabetic retinopathy condition. PMID: 27422995
- Galectin-3 and fibulin-1 levels are elevated in heart failure patients with impaired glucose metabolism. Reduced LV contractile reserve among HF patients with DM does not to have an independent impact on plasma Gal-3 and fibulin-1 levels. PMID: 28068900
- changes in methylation levels in cfDNA associated with hepatocellular carcinoma and could represent useful plasma-based biomarker PMID: 28333958
- The FBLN1/FGF8 interaction may also be involved in the survival of neural crest cell population during development. PMID: 27402846
- Low expression of fibulin-1 is associated with gastric cancer. PMID: 26779638
- LDH associated positively with fibulin-1 (beta = 0.23; p < 0.001) and ROS (beta = 0.11; p = 0.30) in blacks only with cardiovascular disease. PMID: 26631026
- The procedure described is the first to our knowledge that enables a large scale purification of Fibulin-1 from human plasma. PMID: 26826315
- Study identifies a novel fibulin-1D variant, named fibulin-1D', comprising 638 amino acids with molecular weight of 70.5 kDa. Fibulin-1D' lacks a secretion sequence, has a truncated N-terminus domain and binds to the intracellular domain of integrin beta1. PMID: 25661773
- The purpose of this study was to develop and characterize robust quantitative assays for the emerging cardiovascular biomarker fibulin-1 and its circulating isoforms in human plasma. PMID: 25331251
- Extracellular matrix biomarker, fibulin-1 and its association with soluble uPAR in a bi-ethnic South African population PMID: 25456503
- Treatment with low-dose spironolactone reduced plasma fibulin-1 levels in patients with type 2 diabetes and resistant hypertension. PMID: 24739800
- fibulin-1 expression is associated with NMIBC grade and recurrence, it is epigenetically down-regulated and functions as a tumor suppressor gene and angiogenesis inhibitor in bladder cancer. PMID: 25234557
- Plasma fibulin-1 is independently associated with pulse wave velocity in type 2 diabetics. PMID: 23866070
- Increased levels of fibulin-1 were independently associated with higher levels of suPAR and NT-proBNP especially in patients with lower aortic valve stenosis PMID: 25014213
- Mutation of fibulin-1 causes a novel syndrome involving the central nervous system and connective tissues. PMID: 24084572
- FBLN1 functions as a novel candidate tumor suppressor gene in CM, and its downregulation may be due to promoter hypermethylation. PMID: 23907575
- Increased plasma fibulin-1 levels are associated with diabetes and impaired kidney function. PMID: 23294625
- Fibulin-1 is down regulated in renal cell carcinoma through promoter hypermethylation. PMID: 23391467
- In single regression analysis, NT-proBNP was significantly associated with fibulin-1 in African men and Caucasian women. PMID: 22349089
- Fibulin-1 is down-regulated in atrial tissue from patients with atrial fibrillation, perhaps reflecting the myocardial structural changes that may have taken place during arrhythmia. PMID: 20451270
- plasma levels of fibulin-1 could serve as a potential indicator to monitor kidney malfunction or kidney damage PMID: 21888404
- Fibulin-1 accumulates in the arterial wall and in plasma of patients with type 2 diabetes, and appears to be a factor associated with arterial extracellular matrix changes in type 2 diabetes. PMID: 21926180
- Promoter hypermethylation of FBLN1 was significantly associated with advanced stage hepatocellular carcinoma, multiple tumors and increased tumor size. PMID: 21268132
- data collectively suggest fibulin-1C may be worthy of further investigation as a target for airway remodeling in asthma PMID: 20967215
- Fibulin-1 protein was expressed in guinea pig sclera and cultured human scleral fibroblasts. PMID: 20405022
- the pattern of fibulin-1 within human atherosclerotic lesions and the potential for fibulin-1, perhaps derived from the blood and acting in conjunction with fibrinogen, to play a role in the etiology and cardiovascular disease progression PMID: 19693531
- Fibulin-1 has pronounced inhibitory effects on cell attachment and spreading promoted by fibronectin (FN) and suppresses the motility of a variety of cell types on FN substrates. PMID: 11792823
- structural and functional characterization of promoter PMID: 11829738
- FBLN1 disrupted by a t(12;22) translocation is associated with a complex type of synpolydactyly. PMID: 11836357
- binding of HPV E6 protein to fibulin-1 PMID: 12200142
- findings indicate that elevated expression and altered processing of fibulin-1 is associated with human breast cancer PMID: 12644824
- The gene responsible for a unique vitreoretinal dystrophy is located on chromosome 22q13. PMID: 12912698
- mutations in the splice acceptor site of fibulin-1 exon 19, but no MYH9 mutations,were found in family individuals affected by autosomal-dominant giant platelet syndromes associated with aberrant antisense gene regulation of the fibulin-1 gene. PMID: 14635206
- FBLN seems to have an immunological and pathobiological role in breast neoplasm surveillance. PMID: 14691454
- The preferential induction of the fibulin-1C variant, which is overexpressed in ovarian and breast cancer, might play an important role in estrogen-promoted carcinogenesis. PMID: 15528301
- fiblin-1 is an important molecule that mediates progesterone action in human endometrial stromal cells differentiation towards implantation PMID: 15774544
- fibulin-1 is a new regulator of ADAMTS-1-mediated proteoglycan proteolysis and may play an important role in proteoglycan turnover in tissues where there is overlapping expression PMID: 16061471
- Coexpression of fibulin-1 with GROalpha abrogates key aspects of the transformed phenotype, including colonic tumor formation in a murine xenograft model. PMID: 17062666
- degradation of basement membrane by cathepsin D liberates both fibulin-1 fragments and fibulin-5, which function to inhibit angiogenesis PMID: 18222970
- FBLN1 was identified as a novel candidate tmour suppressor gene epigenetically downregulated in gastric cancer PMID: 18985039
- Like tenascin-C, fibulin-1 inhibits fibroblast spreading and cell-mediated contraction of a fibrin-fibronectin matrix. PMID: 19109427
- fibulin-1 and -2 respond differentially to single and repeated damaging noxae, and their expression is differently present in liver cells PMID: 19609566
顯示更多
收起更多
-
相關(guān)疾病:A chromosomal aberration involving FBLN1 is found in a complex type of synpolydactyly referred to as 3/3-prime/4 synpolydactyly associated with metacarpal and metatarsal synostoses. Reciprocal translocation t(12;22)(p11.2;q13.3) with RASSF8. Fibroblasts derived from a patient with synpolydactyly displayed alterations in the level of isoform D splice variant incorporated into the ECM and secreted into the conditioned culture medium. By contrast, the expression of isoform C was not perturbed in the patients fibroblasts. Furthermore, no aberrant polypeptides were detected in extracts of cultured patients fibroblasts. The translocation t(12;22) may result in haploinsufficiency of the isoform D splice variant, which could lead to the observed limb malformation.
-
亞細(xì)胞定位:Secreted, extracellular space, extracellular matrix.
-
蛋白家族:Fibulin family
-
組織特異性:Isoform A and isoform B are only expressed in placenta. Isoform C and isoform D are expressed in a variety of tissues and cultured cells.
-
數(shù)據(jù)庫鏈接:
Most popular with customers
-
-
YWHAB Recombinant Monoclonal Antibody
Applications: ELISA, WB, IHC, IF, FC
Species Reactivity: Human, Mouse, Rat
-
Phospho-YAP1 (S127) Recombinant Monoclonal Antibody
Applications: ELISA, WB, IHC
Species Reactivity: Human
-
-
-
-
-